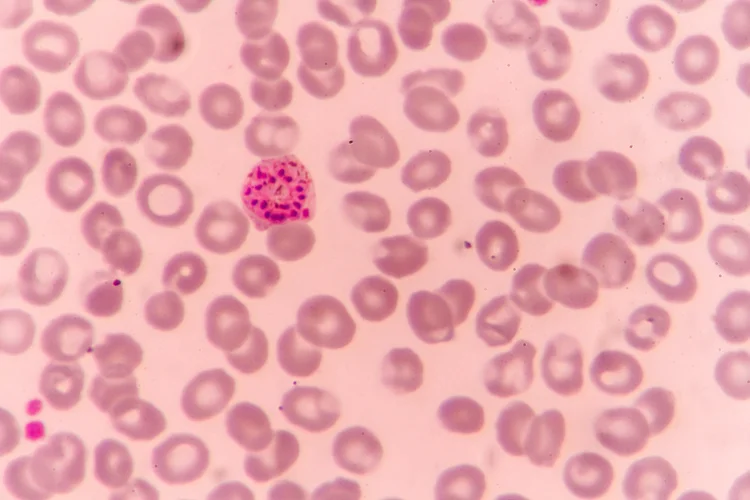

Malaria Pills Singapore
Medication | Malaria Pill |
Purpose | Used for the prevention and treatment of malaria infection in travellers and patients. |
Recommended For | Travellers visiting areas where malaria transmission occurs, based on medical advice. |
Price | From $1.09 to $15.59 per tablet, NETT and inclusive of GST (depending on medication type). |
Appointment Options |
Same-day appointment (subject to availability). Book via WhatsApp: 8893 3757 or email: hello@healthscreening.sg |
Clinic Locations |
Orchard: 1 Orchard
Blvd #05-09 Camden Medical Centre, S248649 Tanjong Pagar: 72 Anson Rd #01-02 Anson House, S079911 |
What Are Malaria Pills?
Malaria pills are prescription medicines that help protect against or treat malaria, an illness caused by Plasmodium parasites spread through bites from infected Anopheles mosquitoes. They are most often advised for individuals travelling to areas where malaria transmission is frequent or ongoing.

When Should You Take Malaria Pills?
Whether you need malaria pills depends on several factors that influence your risk of infection:
- Destination – Malaria risk differs across and within countries, with higher exposure in parts of Africa, Asia, the Americas, the Pacific Islands, and the Middle East. You can refer to sources such as the CDC Yellow Book for up-to-date malaria risk maps and travel advice.
- Length of Stay – Spending extended periods in endemic regions increases the chances of mosquito bites and infection.
- Health Status – Pre-existing medical conditions, allergies, or medications you are taking may affect which antimalarial drug is suitable.
Before your trip, consult your doctor to review your travel plans, health condition, and destination-specific risks so they can recommend the most suitable malaria prevention medication for you.
How Do Malaria Pills Work?
Malaria pills prevent infection by disrupting the lifecycle of the Plasmodium
parasite inside the human body. When a mosquito carrying the parasite bites
a person, the parasite enters the bloodstream and eventually infects the liver and red blood
cells. Antimalarial drugs interfere with this process, either killing the parasites or stopping them from multiplying
further.
For effective protection, the medication should be started before travelling to malaria-risk
areas so that adequate drug levels are present in the blood upon arrival. The course is
continued throughout the trip and for a prescribed period after returning home to eliminate any
parasites that may still be developing.
What Are Types of Malaria Pills?
There are several types of malaria pills available, each formulated with different active ingredients and dosing schedules, and associated with varying side effects. Common options include:
Types of Malaria Pills | Description |
---|---|
Atovaquone-Proguanil | A once-daily tablet used for both prevention and treatment of malaria. It is well tolerated and suitable for short-term travel. |
Doxycycline | A daily antibiotic used to prevent malaria. It is commonly prescribed for travellers and relatively affordable. |
Mefloquine | A weekly medication that can be used for both prevention and treatment, often recommended for longer trips. |
Chloroquine | Used for prevention and treatment only in areas where malaria parasites are still sensitive to this drug, as resistance is common in many regions. |
When Should You Take Malaria Pills?
Malaria pills are taken before travelling to areas where malaria is present, continue throughout
your trip, and complete the course after returning home. The exact timing depends on the specific medication prescribed and must be
followed closely to ensure full protection.
General recommendations include:
- Before travel – Start the medication 1 to 2 days before entering a malaria-prone area. Some drugs may need to begin up to a week in advance.
- During travel – Take the tablets regularly at the same time each day or week, depending on the prescribed drug, and avoid missing doses.
- After travel – Continue taking the medication for 1 to 4 weeks after leaving the malaria-risk area, as directed by your doctor, to clear any remaining parasites.

Always adhere to your doctor’s instructions and complete the full course to maintain protection and prevent infection.
Are There Side Effects of Malaria Pills?
Like many medications, malaria pills may cause side effects, which can differ from person to person. Most
reactions are mild and temporary, while serious effects are less common.
Common mild side effects include:
- Nausea, stomach discomfort, or vomiting – may occur with several antimalarial drugs, especially when taken on an empty stomach.
- Dizziness or light-headedness – can occasionally happen with atovaquone-proguanil or mefloquine.
- Increased sensitivity to sunlight – commonly associated with doxycycline; travellers should use sunscreen and limit prolonged sun exposure.
Less frequent side effects may involve:
- Mood changes, anxiety, or vivid dreams – sometimes reported with mefloquine.
- Allergic reactions or skin rashes – may occur with various medications, though these are uncommon.
- Severe abdominal pain or depression – rare but warrant immediate medical attention.
If you experience persistent or severe symptoms, consult a doctor promptly for further evaluation or an
alternative prescription.
Disclaimer: The information provided is for general educational purposes and should
not be taken as medical advice. Always seek guidance from a qualified healthcare professional before
beginning any malaria medication or travel-related treatment.
What Is the Cost of Malaria Pills?
At healthscreening.sg, we provide the following malaria medications, with prices listed below:
Medication | Price* |
---|---|
Consultation | From $49.05 |
Malarone (Atovaquone-Proguanil) Typical Dosage: 2 days + duration of travel + 7 days after returning (1 tab per day) |
$15.59 per tab |
Doxycycline Typical Dosage: 2 days + duration of travel + 28 days after returning (1 tab per day) |
$1.09 per tab |
*Prices are NETT and inclusive of GST.
We also offer a comprehensive range of travel-related vaccinations, a travel medical kit, and preventive
health services to support your travel needs.
Where to Buy Malaria Pills in Singapore?
Why Choose Us?






Navigate Easy With Google Maps
Health Screening Singapore
(Anson House)
Health Screening Singapore
(Camden Medical Centre)
Frequently Asked Questions (FAQ)
You should consider taking malaria pills if you are travelling to a region where malaria transmission occurs, as they significantly reduce your risk of infection. The decision depends on your destination, trip duration, and personal health. In high-risk areas, preventive medication is generally recommended as part of travel health precautions. It is advisable to consult your doctor before travelling to determine the most suitable antimalarial medication for your needs.
You may need malaria pills when travelling to certain parts of South Africa where malaria transmission still occurs, particularly in some northeastern and low-lying regions. Major urban centres such as Johannesburg, Cape Town, and Durban are malaria-free. It is advisable to consult your doctor before your trip to assess your itinerary and determine whether preventive medication is necessary.
When taking malaria pills, avoid skipping doses, consuming excessive alcohol, or stopping the course early, as these reduce the medication’s effectiveness. Some drugs, such as doxycycline, should not be taken with dairy products or antacids, as these can interfere with absorption. Limiting sun exposure is also important when taking doxycycline due to increased photosensitivity. Always follow your doctor’s instructions regarding dosage, timing, and possible interactions with other medications.
If you forget to take a malaria pill, take it as soon as you remember. If it is nearly time for your next dose, skip the missed one and continue with your usual schedule. Avoid taking two doses at once, as this may increase side effects. Missing doses can reduce protection and raise your risk of infection. If you miss several doses, it is advisable to consult your doctor for guidance.
Most side effects of malaria pills are mild and temporary, resolving within a few days once your body adjusts or after you stop taking the medication. Common effects include nausea, dizziness, or mild stomach discomfort. In rare cases, side effects may persist longer or become more severe, particularly with drugs like mefloquine. If symptoms continue beyond a few days or interfere with daily activities, it is advisable to consult your doctor for assessment or a change in medication.
There is no single “strongest” or “best” malaria drug, as the most suitable option depends on your travel destination, duration of stay, and health condition. Atovaquone-proguanil and doxycycline are among the most commonly prescribed medications for malaria prevention. Your doctor can advise on the most appropriate option based on where you are travelling and your personal health needs.
Malaria pills work by killing or preventing the growth of Plasmodium parasites transmitted through mosquito bites. These drugs act at different stages of the parasite’s lifecycle in the liver and red blood cells, reducing the risk of infection or helping to treat existing disease. Starting the course before travel and continuing it after return ensures full protection. Always follow the dosage and duration recommended by your doctor.
Malaria does not usually go away without treatment and can quickly become severe or life-threatening if left untreated. The infection causes symptoms such as fever, chills, headache, and fatigue, which may worsen over time as the parasites continue multiplying in the blood. Prompt medical treatment with antimalarial medication is essential to clear the infection and prevent serious complications. If you develop these symptoms after travel, it is advisable to consult a doctor immediately.
Malaria pills are advised for travellers visiting parts of India where malaria transmission still occurs, especially in rural or forested areas. The risk is generally low in major cities such as Delhi, Mumbai, and Chennai. Whether you need preventive medication depends on your travel route, length of stay, and season. It is advisable to consult your doctor before travelling to determine if malaria pills are necessary for your trip.
Taking malaria tablets after being bitten does not provide immediate protection against infection already transmitted by the mosquito. However, continuing or starting the medication as advised can still help prevent further infection if you remain in a risk area. If you develop symptoms such as fever, chills, or body aches after a bite, it is advisable to seek prompt medical evaluation for possible treatment.
The first symptoms of malaria typically include fever, chills, headache, muscle pain, and fatigue, which may appear 7 to 30 days after infection. Some people may also experience nausea, vomiting, or sweating. Because these symptoms resemble flu or viral infections, malaria can sometimes go unrecognised. If you develop these symptoms after visiting a malaria-risk area, it is advisable to consult a doctor immediately for testing and treatment.
Malaria tablets are recommended for travel to regions where malaria transmission is common, including most of sub-Saharan Africa, parts of South and Southeast Asia, Central and South America, the Pacific Islands, and areas of the Middle East. The risk varies by country and even within regions, so it is important to check current malaria maps from sources such as the CDC or WHO before travelling.
If you travel to a malaria-endemic area without taking preventive medication, you risk contracting malaria through mosquito bites. The infection can cause fever, chills, fatigue, and in severe cases, life-threatening complications. Even short-term travellers can be affected, and there is no guaranteed natural immunity. It is advisable to consult your doctor before your trip to determine if malaria pills are needed for your destination.
Most people tolerate malaria pills well, although some may experience mild, temporary side effects such as nausea, dizziness, or stomach discomfort. Sensitivity to sunlight may occur with doxycycline, while vivid dreams or mood changes can happen with mefloquine. These effects usually resolve once your body adjusts or after the course is completed. If side effects persist or become troublesome, it is advisable to consult your doctor for further advice.
Malaria pills are generally recommended for travellers visiting rural or forested regions of Cambodia, where some transmission risk remains. The risk in major cities such as Phnom Penh and Siem Reap is considered very low. Whether you need preventive medication depends on your itinerary, travel season, and duration of stay. It is advisable to consult your doctor before your trip for guidance on suitable malaria prevention measures.